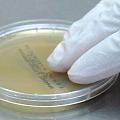
Готовые среды с β-лактамазой

Сухие и готовые питательные среды HIMEDIA
Компания HiMEDIA производит среды, отвечающие мировым стандартам качества. Готовые среды в чашках Петри и во флаконах для фармацевтической и пищевой промышленности, производителей напитков, контактные чашки для гигиенического мониторинга, готовые среды для контроля стерильности.Производство питательных сред полностью отвечает стандартам качества , пред’являемых для фармацевтической промышленности, система менеджмента качества сертифицирована по ISO 9001:2015.
Осуществляется тщательный контроль сырья и полупродуктов на каждой стадии производства сред и готовой продукции. Каждая партия питательных сред сопровождается сертификатом качества.
Мы поможем вам подобрать питательные среды, предоставим сертификаты качества и техническую информацию.
Также, в наличии и под заказ широкий перечень продукции для лабораторного применения и микробиологии с использованием метода мембранной фильтрации и сухие питательные среды HiMedia.
|
Наши специалисты ответят на любой интересующий вопрос
|
Задать вопрос
|
Документация
|
Быстрый просмотр
|
Артикул: GRM151
|
Запросить стоимость
|
|
Быстрый просмотр
|
Артикул: GRM10997
|
Запросить стоимость
|